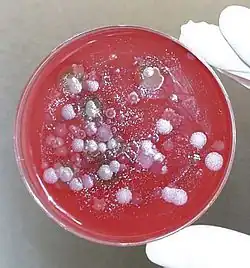

Biological agent
| Weapons of mass destruction |
|---|
 |
| By type |
|
| By country |
|
| Non-state |
| Islamic State |
| Nuclear weapons by country |
|
| Proliferation |
|
| Treaties |
|
|
Biological agents, also known as biological weapons or bioweapons, are pathogens used as weapons. In addition to these living or replicating pathogens, toxins and biotoxins are also included among the bio-agents. More than 1,200 different kinds of potentially weaponizable bio-agents have been described and studied to date, and experts expect that in the future it will be possible to design novel biological weapons[2].
Some biological agents have the ability to adversely affect human health in a variety of ways, ranging from relatively mild allergic reactions to serious medical conditions, including serious injury, as well as serious or permanent disability or death. Many of these organisms are ubiquitous in the natural environment where they are found in water, soil, plants, or animals.[3] Bio-agents may be amenable to "weaponization" to render them easier to deploy or disseminate. Genetic modification may enhance their incapacitating or lethal properties, or render them impervious to conventional treatments or preventives. Since many bio-agents reproduce rapidly and require minimal resources for propagation, they are also a potential danger in a wide variety of occupational settings.[3]
The 1972 Biological Weapons Convention is an international treaty banning the development, use or stockpiling of biological weapons; as of March 2021, there were 183 states parties to the treaty.[4] Bio-agents are, however, widely studied for both defensive and medical research purposes under various biosafety levels and within biocontainment facilities throughout the world.
Classifications
Operational
The former United States biological weapons program (1943–1969) categorized its weaponized anti-personnel bio-agents as either "lethal agents" (Bacillus anthracis, Francisella tularensis, Botulinum toxin) or "incapacitating agents" (Brucella suis, Coxiella burnetii, Venezuelan equine encephalitis virus, staphylococcal enterotoxin B).[5]
Legal
Since 1997, United States law has declared a list of bio-agents designated by the U.S. Department of Health and Human Services or the U.S. Department of Agriculture that have the "potential to pose a severe threat to public health and safety" to be officially defined as "select agents" and possession or transportation of them are tightly controlled as such.[6] Select agents are divided into "HHS select agents and toxins", "USDA select agents and toxins" and "Overlap select agents and toxins".
Regulatory
The US Centers for Disease Control and Prevention (CDC) breaks biological agents into three categories: Category A, Category B, and Category C. Category A agents pose the greatest threat to the US. Criteria for being a Category "A" agent include high rates of morbidity and mortality, ease of dissemination and communicability, ability to cause a public panic, and special action required by public health officials to respond. Category A agents include anthrax, botulism, plague, smallpox, and viral hemorrhagic fevers.
List of bio-agents of military importance
- The following pathogens and toxins were weaponized by one nation or another at some time. NATO abbreviations are included where applicable.
Bacterial bio-agents
| Disease | Causative agent (military symbol) |
|---|---|
| Anthrax | Bacillus anthracis (N or TR) |
| Brucellosis (bovine) | Brucella abortus |
| Brucellosis (caprine) | Brucella melitensis (AM or BX) |
| Brucellosis (porcine) | Brucella suis (US, AB or NX) |
| Cholera | Vibrio cholerae (HO) |
| Diphtheria | Corynebacterium diphtheriae (DK) |
| Dysentery (bacterial) | Shigella dysenteriae, Escherichia coli (Y) |
| Glanders | Burkholderia mallei (LA) |
| Listeriosis | Listeria monocytogenes (TQ) |
| Melioidosis | Burkholderia pseudomallei (HI) |
| Plague | Yersinia pestis (LE) |
| Tularemia | Francisella tularensis (SR or JT) |
Chlamydial bio-agents
| Disease | Causative agent (military symbol) |
|---|---|
| Psittacosis | Chlamydophila psittaci (SI) |
Rickettsial bio-agents
| Disease | Causative agent (military symbol) |
|---|---|
| Q fever | Coxiella burnetii (OU) |
| Rocky Mountain spotted fever | Rickettsia rickettsii (RI or UY) |
| Typhus (human) | Rickettsia prowazekii (YE) |
| Typhus (murine) | Rickettsia typhi (AV) |
Viral bio-agents
| Disease | Causative agent (military symbol) | Comments |
|---|---|---|
| Equine encephalitis (Eastern) | Eastern equine encephalitis virus (ZX) | |
| Equine encephalitis (Venezuelan) | Venezuelan equine encephalitis virus (FX) | |
| Equine encephalitis (Western) | Western equine encephalitis virus (EV) | |
| Japanese B encephalitis | Japanese encephalitis virus (AN) | |
| Marburg hemorrhagic fever (Marburg HF) | Marburg virus (MARV) | by the Soviet Union[7] |
| Rift Valley fever | Rift Valley fever virus (FA) | |
| Smallpox | Variola virus (ZL) | |
| Yellow fever | Yellow fever virus (OJ or LU) |
Mycotic bio-agents
| Disease | Causative agent (military symbol) |
|---|---|
| Coccidioidomycosis | Coccidioides immitis (OC) |
Biological toxins
| Toxin | Source of toxin (military symbol) |
|---|---|
| Abrin | Rosary pea (Abrus precatorius) |
| Botulinum toxins (A through G) | Clostridium botulinum bacteria or spores, and several other Clostridial species. (X or XR) |
| Ricin | Castor bean (Ricinus communis) (W or WA) |
| Saxitoxin | Various marine and brackish cyanobacteria, such as Anabaena, Aphanizomenon, Lyngbya, and Cylindrospermopsis (TZ) |
| Staphylococcal enterotoxin B | Staphylococcus aureus (UC or PG) |
| Tetrodotoxin | Various marine bacteria, including Vibrio alginolyticus, Pseudoalteromonas tetraodonis (PP) |
| Trichothecene mycotoxins | Various species of fungi, including Fusarium, Trichoderma, and Stachybotrys |
Biological vectors
| Vector (military symbol) | Disease |
|---|---|
| Mosquito (Aedes aegypti) (AP) | Malaria, Dengue fever, chikungunya, yellow fever, other arboviruses |
| Oriental flea (Xenopsylla cheopis) | Plague, murine typhus |
Simulants
Simulants are organisms or substances which mimic physical or biological properties of real biological agents, without being pathogenic. They are used to study the efficiency of various dissemination techniques or the risks caused by the use of biological agents in bioterrorism.[8] To simulate dispersal, attachment or the penetration depth in human or animal lungs, simulants must have particle sizes, specific weight and surface properties, similar to the simulated biological agent.
The typical size of simulants (1–5 μm) enables it to enter buildings with closed windows and doors and penetrate deep into the lungs. This bears a significant health risk, even if the biological agent is normally not pathogenic.
- Bacillus globigii (historically named Bacillus subtilis in the context of bio-agent simulants) (BG, BS, or U)
- Serratia marcescens (SM or P)
- Aspergillus fumigatus mutant C-2 (AF)
- Escherichia coli (EC)
- Bacillus thuringiensis (BT)
- Erwinia herbicola (current accepted name: Pantoea agglomerans) (EH)
- Fluorescent particles such as zinc cadmium sulfide, ZnCdS (FP)
International law

While the history of biological weapons use goes back more than six centuries to the siege of Caffa in 1346,[10] international restrictions on biological weapons began only with the 1925 Geneva Protocol, which prohibits the use but not the possession or development of chemical and biological weapons in international armed conflicts.[11] Upon ratification of the Geneva Protocol, several countries made reservations regarding its applicability and use in retaliation.[12] Due to these reservations, it was in practice a "no-first-use" agreement only.[13]
The 1972 Biological Weapons Convention supplements the Geneva Protocol by prohibiting the development, production, acquisition, transfer, stockpiling and use of biological weapons.[14] Having entered into force on 26 March 1975, this agreement was the first multilateral disarmament treaty to ban the production of an entire category of weapons of mass destruction.[14] As of March 2021, 183 states have become party to the treaty.[4] The treaty is considered to have established a strong global norm against biological weapons,[15] which is reflected in the treaty's preamble, stating that the use of biological weapons would be "repugnant to the conscience of mankind".[16] However, its effectiveness has been limited due to insufficient institutional support and the absence of any formal verification regime to monitor compliance.[17]
In 1985, the Australia Group was established, a multilateral export control regime of 43 countries aiming to prevent the proliferation of chemical and biological weapons.[18]
In 2004, the United Nations Security Council passed Resolution 1540, which obligates all UN Member States to develop and enforce appropriate legal and regulatory measures against the proliferation of chemical, biological, radiological, and nuclear weapons and their means of delivery, in particular, to prevent the spread of weapons of mass destruction to non-state actors.[19]
See also
- Biological hazard
- Biological contamination
- Laboratory Response Network
- Pulsed ultraviolet light
References
- ↑ "「標本室は目の開けられないくらい・・・」731部隊の実態、元少年兵の目に焼きついた光景【報道特集】". TBS News. 21 April 2024. Retrieved 2024-07-02.
- ↑ Manheim, David; Williams, Adeline; Aveggio, Casey; Berke, Allison (2025). Understanding the Theoretical Limits of AI-Enabled Pathogen Design: Insights from a Delphi Study (Research Report). RAND Research Report. Santa Monica, CA: RAND Corporation. p. 123. doi:10.7249/RRA4087-1. Retrieved 29 October 2025.
- 1 2 "Biological Agents". United States Department of Labor: OSHA. Retrieved 2012-05-31.
- 1 2 "Disarmament Treaties Database: Biological Weapons Convention". United Nations Office for Disarmament Affairs. Archived from the original on 2013-03-03. Retrieved 2021-03-02.
- ↑ Headquarters, Departments of the Army, the Navy, and the Air Force, and Commandant, Marine Corps (17 July 2000), Field Manual: Treatment of Biological Warfare Casualties (Army FM 8-284/Navy NAVMED P-5042/Air Force AFMAN (I) 44-156/Marine Corps MCRP 4-11.1C), para 1-4 (pg 1-3).
- ↑ Additional Requirements for Facilities Transferring or Receiving Select Agents, Title 42 CFR Part 72 and Appendix A; 15 April 1997 (DHHS).
- ↑ Kenneth Alibek and S. Handelman. Biohazard: The Chilling True Story of the Largest Covert Biological Weapons Program in the World - Told from Inside by the Man Who Ran it. 1999. Delta (2000) ISBN 0-385-33496-6.
- ↑ "Biological Warfare (BW) Simulants – Bacillus globigii (BG)". The Night Ferry. 2010-02-05. Retrieved 2017-04-03.
- ↑ United Nations (1972). Biological Weapons Convention.
- ↑ Wheelis, Mark (September 2002). "Biological Warfare at the 1346 Siege of Caffa". Emerging Infectious Diseases. 8 (9): 971–975. doi:10.3201/eid0809.010536. PMC 2732530. PMID 12194776.
- ↑ "Text of the 1925 Geneva Protocol". United Nations Office for Disarmament Affairs. Archived from the original on 2015-04-08. Retrieved 2021-03-02.
- ↑ "Disarmament Treaties Database: 1925 Geneva Protocol". United Nations Office for Disarmament Affairs. Archived from the original on 2013-08-25. Retrieved 2021-03-02.
- ↑ Beard, Jack M. (April 2007). "The Shortcomings of Indeterminacy in Arms Control Regimes: The Case of the Biological Weapons Convention". American Journal of International Law. 101 (2): 277. doi:10.1017/S0002930000030098. ISSN 0002-9300. S2CID 8354600.
- 1 2 "Biological Weapons Convention". United Nations Office for Disarmament Affairs. Archived from the original on 2021-02-15. Retrieved 2021-03-02.
- ↑ Cross, Glenn; Klotz, Lynn (2020-07-03). "Twenty-first century perspectives on the Biological Weapon Convention: Continued relevance or toothless paper tiger". Bulletin of the Atomic Scientists. 76 (4): 185–191. Bibcode:2020BuAtS..76d.185C. doi:10.1080/00963402.2020.1778365. ISSN 0096-3402.
- ↑ "Preamble, Biological Weapons Convention". United Nations Office for Disarmament Affairs. Archived from the original on 2014-03-06. Retrieved 2021-03-02.
- ↑ Dando, Malcolm (2006). Chapter 9: The Failure of Arms Control, In Bioterror and Biowarfare: A Beginner's Guide. Oneworld. pp. 146–165. ISBN 9781851684472.
- ↑ "The Origins of the Australia Group". Australian Department of Foreign Affairs and Trade. Archived from the original on 2021-03-02. Retrieved 2021-03-02.
- ↑ "1540 Committee". United Nations. Archived from the original on 2020-02-20. Retrieved 2021-03-02.
External links
- Rafał L. Górny, Biological agents, OSHwiki (Archived 2023-01-30 at the Wayback Machine)
- Biological Agents, OSHA
- Select Agents and Toxins, Centers for Disease Control and Prevention
- Biological weapons e-learning module in the EU's non-proliferation and disarmament course (taught by Filippa Lentzos)